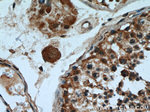
SHCBP1 Antibody in Immunohistochemistry (Paraffin) (IHC (P))
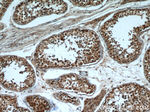
SHCBP1 Antibody in Immunohistochemistry (Paraffin) (IHC (P))

Search
Proteintech
SHCBP1 Polyclonal Antibody
{{$productOrderCtrl.translations['antibody.pdp.commerceCard.promotion.promotions']}}
{{$productOrderCtrl.translations['antibody.pdp.commerceCard.promotion.viewpromo']}}
{{$productOrderCtrl.translations['antibody.pdp.commerceCard.promotion.promocode']}}: {{promo.promoCode}} {{promo.promoTitle}} {{promo.promoDescription}}. {{$productOrderCtrl.translations['antibody.pdp.commerceCard.promotion.learnmore']}}
产品信息
12672-1-AP
种属反应
已发表种属
宿主/亚型
分类
类型
抗原
偶联物
形式
浓度
规格
纯化类型
保存液
内含物
保存条件
运输条件
产品详细信息
Immunogen sequence: NACFEGDTV IVCPGHYVVH GTFSIADSIE LEGYGLPDDI VIEKRGKGDT FVDCTGADIK ISGIKFVQHD AVEGILIVHR GKTTLENCVL QCETTGVTVR TSAEFLMKNS DLYGAKGAGI EIYPGSQCTL SDNGIHHCKE GILIKDFLDE HYDIPKISMV NNIIHNNEGY GVVLVKPTIF SDLQESAEDG TEENKALKIQ TSGEPDVAER VDLEELIECA TGKMELCART DPSEQVEGNC EIVNELIAAS TQKGQIKKKR LSELGITQAD DNLMSQEMFV GIVGNQFKWN GKGSFGTFLF (374-672 aa encoded by BC030699)
靶标信息
May play a role in signaling pathways governing cellular proliferation, cell growth and differentiation. May be a component of a novel signaling pathway downstream of Shc. Acts as a positive regulator of FGF signaling in neural progenitor cells. [UniProt]
仅用于科研。不用于诊断过程。未经明确授权不得转售。
生物信息学
蛋白别名: mPAL; Protein expressed in Activated Lymphocytes; SHC SH2 domain-binding protein 1; SHC-binding protein; unnamed protein product
基因别名: mPAL; PAL; SHCBP1
UniProt ID: (Human) Q8NEM2, (Mouse) Q9Z179
Entrez Gene ID: (Human) 79801, (Mouse) 20419